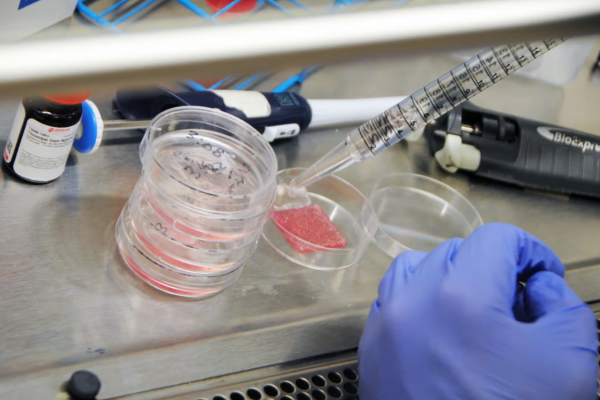

Bilim insanları ilk kez altı temel cilt hücresi tipini özel hidrojellerle birleştirerek kalın, çok katmanlı bir cilt ‘baskı’ yaptı. Bu cilt, nakledildiğinde yaraları daha hızlı ve daha az yara iziyle iyileştirmek için çevredeki dokuyla başarılı bir şekilde bütünleşti.
Wake Forest Rejeneratif Tıp Enstitüsü (WFIRM) direktörü, baş yazar Dr. Anthony Atala, “Kapsamlı cilt iyileşmesi, dünya çapında milyonlarca kişiyi sınırlı seçeneklerle etkileyen önemli bir klinik zorluktur. Bu sonuçlar, biyomühendislik ürünü tam kalınlıkta insan derisi yaratmanın mümkün olduğunu ve daha hızlı iyileşmeyi ve daha doğal görünen sonuçları desteklediğini gösteriyor.”
Keratinositler, dermal fibroblastlar, adipositler, melanositler, folikül dermal papilla hücreleri ve dermal mikrovasküler endotel hücrelerini içeren baskılı cilt, üç katmanla gerçeğini kopyaladı: ince, koruyucu dış epidermis, orta lifli ve destekleyici dermis ve alt kısım. , yağlı hipodermis.
Farelerde büyük bir başarı sağladı
Farelerin yaralarına nakledildiğinde basılan deri kan damarlarını ve deri desenlerini oluşturdu ve normal doku gelişimi gösterdi. Sonuç olarak yaranın daha hızlı kapanması, daha az cilt kasılması ve daha fazla kollajen üretimi, dolayısıyla daha az yara izi elde edildi.
WFIRM ekibi, hücreye özgü boyamayla biyobaskılı hücrelerin iyileşme süreci sırasında yenilenmiş ciltle başarılı bir şekilde bütünleştiğini doğruladı.
Bunu takiben araştırmacılar, bir domuz modelinde tam kalınlıkta bir yarayı kapatmak için daha büyük, 5 cm x 5 cm (2 inç x 2 inç) biyobaskılı domuz derisi grefti kullandılar. Benzer şekilde iyileşmeyi ve kollajen üretimini iyileştirdi ve cilt kasılmasını ve fibrozisi (veya yara izini) azalttı.
İnsan tedavisinde büyük umut vaat ediyor
Daha büyük, otolog greftin başarısı, vücudun diğer bölgelerinden önemli miktarda derinin alınmasının riskli ve sınırlı olduğu insan tedavisinde büyük umut vaat ediyor.
Laboratuvar yapımı cilt, giderek büyüyen bir tıbbi araştırma alanıdır ve şirketler de hayvanları kullanmak yerine ürünleri test etmek için bu yönteme başvurmaktadır. Ancak klinik öncesi çalışmalarda yaranın tamamen iyileştiğini gösteren bu kadar karmaşık ve kalın bir ürün ilk kez üretiliyor. Ekip artık bunun insan çalışmaları için geliştirilmesinden umutlu.
Multicellular bioprinted skin facilitates human-like skin architecture in vivo
Full-thickness skin wounds are often treated with autologous skin grafting, but this option is limited by the volume of skin that can be harvested. Another treatment option consists of dermal skin substitutes, but results are frequently suboptimal. Here, Jorgensen and colleagues incorporated six human skin cell types into a multilayered skin construct through extrusion bioprinting. In vitro, this construct maintained a three-layer structure and matured appropriately. In mice, the construct accelerated wound healing and promoted neovascularization and extracellular matrix remodeling to reduce fibrosis and scar formation. In pigs, grafting with an autologous porcine bioprinted skin contruct led to increased epithelialization and reduced wound contraction, suggesting that bioprinted skin might be an alternative to treat human full-thickness wounds